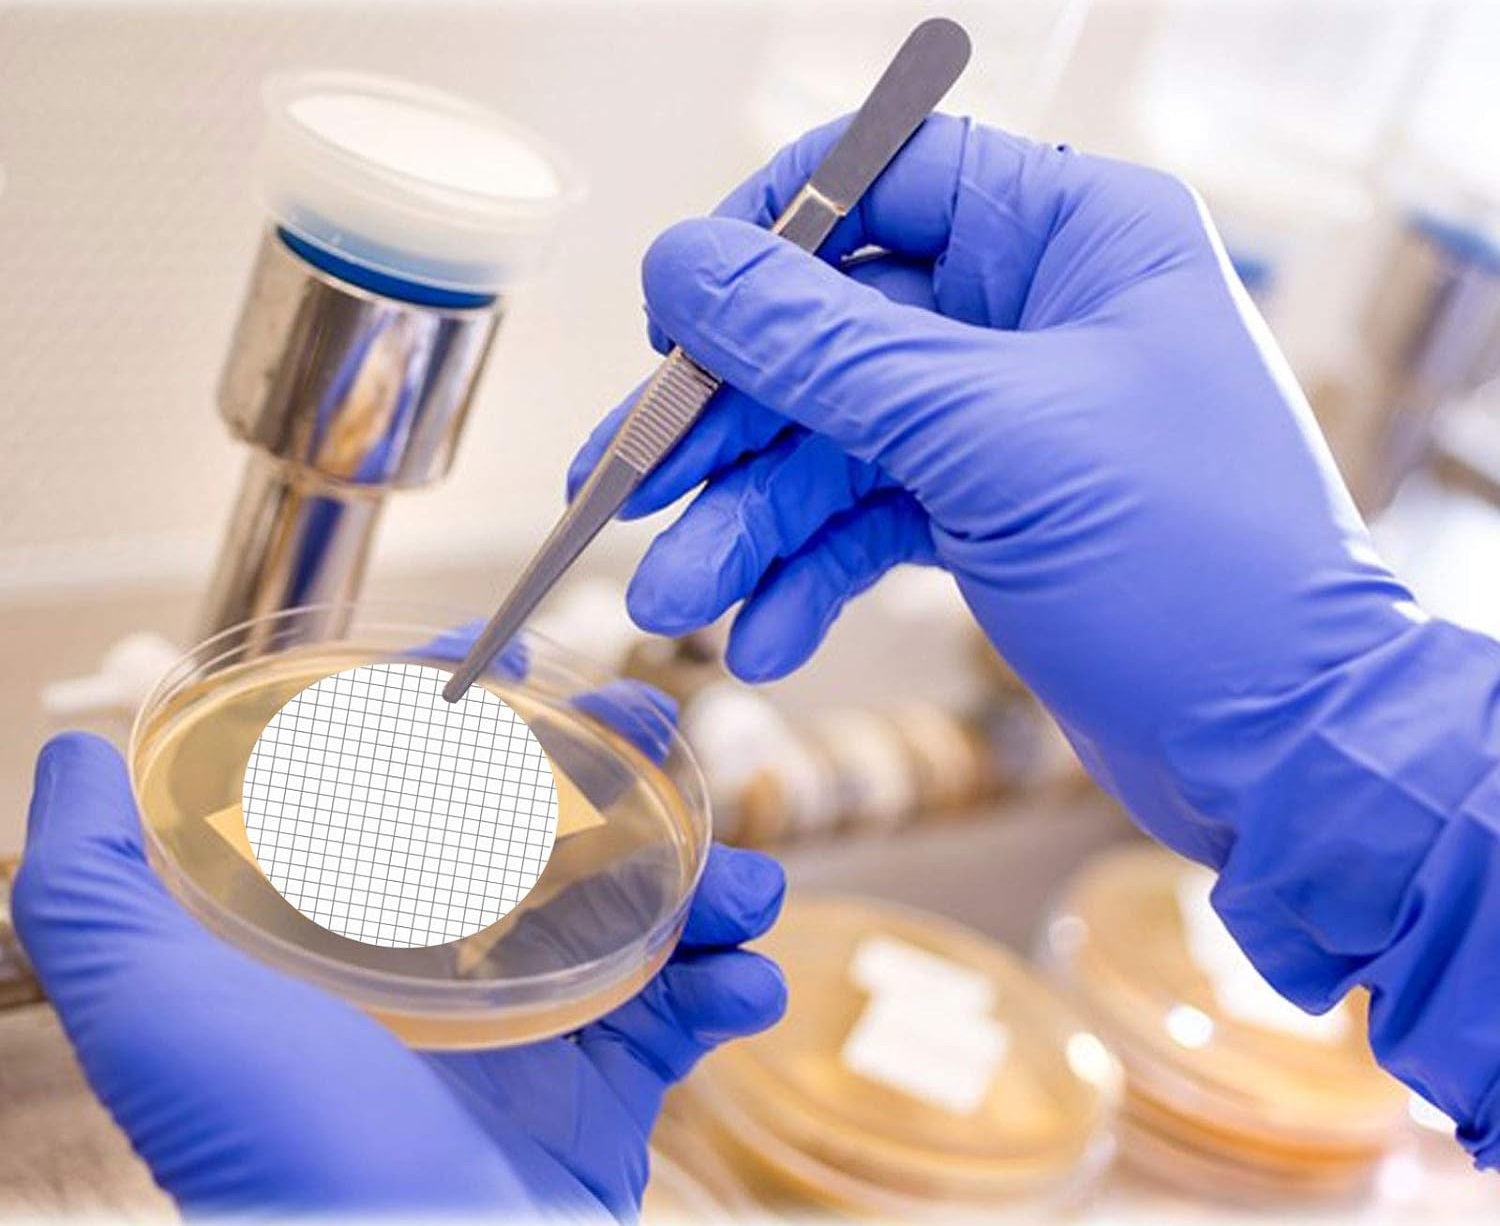

PSFiltration Gridded 0.45um 47mm Mixed Cellulose Esters (MCE) Membrane Filters
0.45 µm
47 mm
Pack/100
MFMCE047045GWS
PSFiltration Gridded 0.45um 47mm Mixed Cellulose Esters (MCE) Membrane Filters are ideal for colony counting and sterility testing. Pre-sterilized and individually packaged gridded MCE membranes are unsupported, naturally hydrophilic membranes composed of cellulose acetate and cellulose nitrate, which has made it one of the most widely used membranes in the examination of water, wastewater, medical, wine, beverage and pharmaceutical industries.
- Clearly defined grid lines spaced at 3.1 mm intervals to assist in manual counting procedures
- Special grid ink is non-toxic and completely free from bacterial growth inhibitors
- Smoother and more uniform surface than pure nitrocellulose filter
- Gamma-irradiated sterilization
- ISO 9001 certifiied and meets ISO 7704 requirements
CAD$ 45 00
Quantity
1
Anything we can help with?
You've got questions, we've got answers.
Reach out and let's see what we can do together.